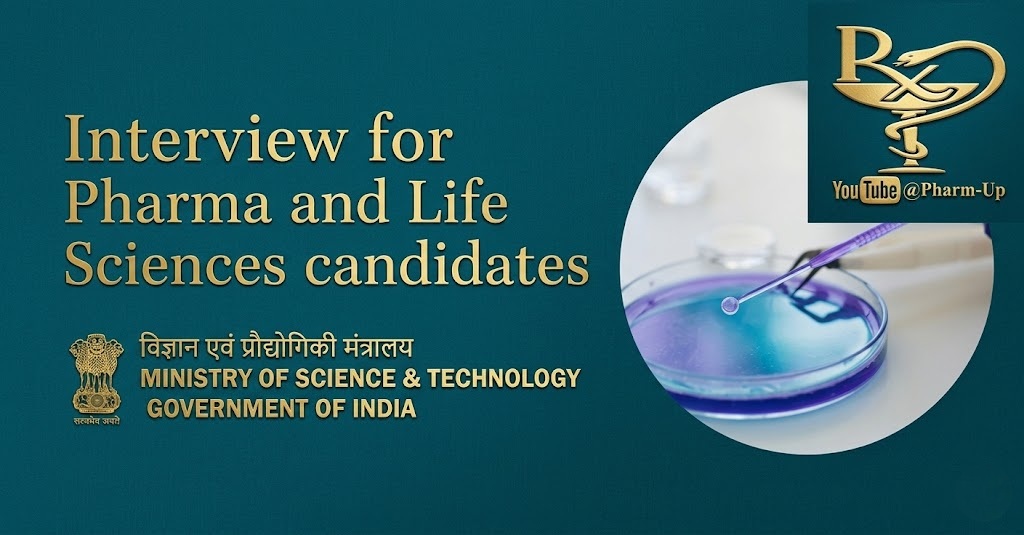

The Biotechnology Research and Innovation Council (BRIC) – Translational Health Science and Technology Institute (THSTI), under the Ministry of Science & Technology, has announced a rolling recruitment for specialized research positions. THSTI is a premier national institute dedicated to translating laboratory innovation into products that improve human health.
Available Research Positions
The institute is looking for qualified professionals to join two critical national projects: Wastewater Surveillance for SARS-CoV-2/Pathogens and the BRIC-Bio Foundry for advanced bio-manufacturing.
- Project Associate-II: Requires an M.Pharm, M.Tech, or Master’s in Life Sciences with 2 years of post-qualification research experience.
- Senior Project Associate: Aimed at candidates with a Master’s in Life Sciences and at least 4 years of experience specifically in Microbiology.
- Principal Project Associate: Open to Ph.D. holders (4 years experience) or Master’s degree holders with 8 years of specialized experience in Microbiology and Microbial Genetics.
Focus Areas & Skills
Candidates will be working on cutting-edge assignments including:
- Genomics-Based Surveillance: Monitoring wastewater for antimicrobial resistance and emerging pathogens.
- Bio-Manufacturing: Culture optimization of aerobic and anaerobic bacteria and animal toxicity studies.
- Multi-omics: Utilizing advanced data integration for environmental biology research.
Walk-in Interview Details
The recruitment will be conducted via walk-in interviews at the NCR Biotech Science Cluster in Faridabad.
- Interview Date: 12th May 2026
- Reporting Time: 9:00 AM
- Virtual Option: Candidates may request a virtual interview by emailing the PI before 7th May 2026.
This is a significant opportunity for researchers to contribute to national health security while working at a top-tier government facility.
